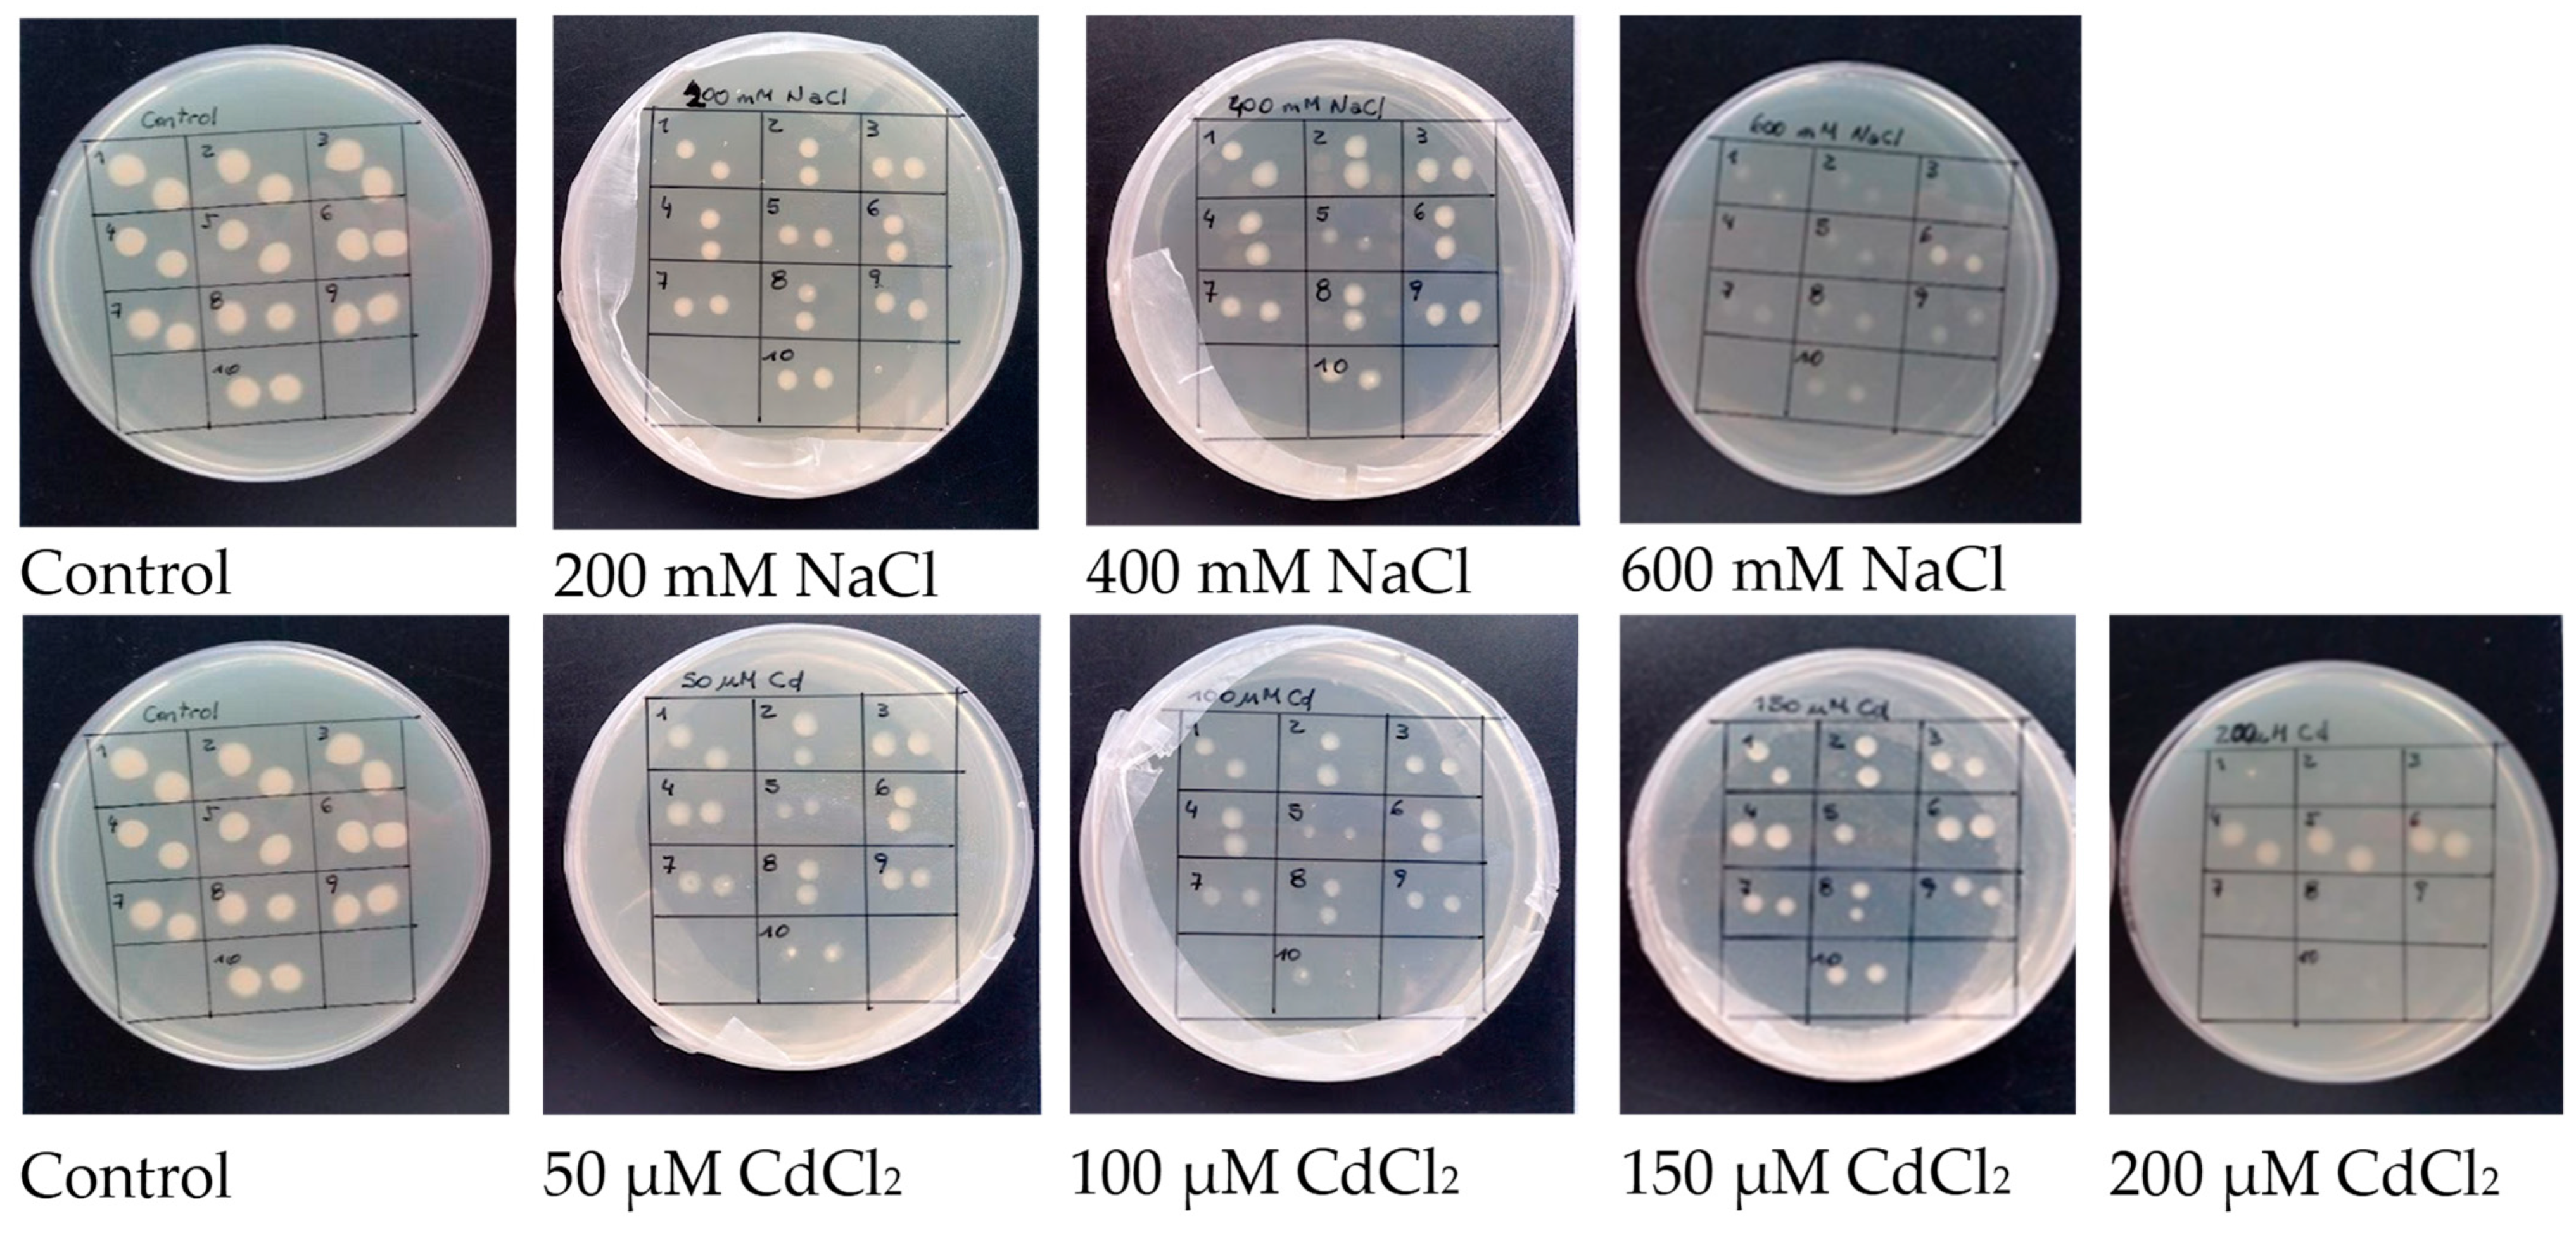
Plants 12 03972 g001

Effects of Inoculation with Stress-Tolerant Rhizobia on the Response of Alfalfa (Medicago sativa L.) to Combined Salinity and Cadmium Stress
Abstract
:1. Introduction
2. Results
2.1. Identification of Rhizobia Tolerant to Salinity and Cd Stress
2.2. Morphological Parameters
2.3. Lipid Peroxidation and Antioxidant Enzymatic Activities
2.4. Cadmium Accumulation
2.5. Real-Time qPCR Analysis
3. Discussion
4. Materials and Methods
4.1. Plant Material, Experimental Design, Treatments, and Growth Conditions
4.2. Isolation and Characterization of Rhizobia
4.3. Lipid Peroxidation and Enzyme Activities
4.4. Cadmium Content
4.5. Real-Time qPCR
4.6. Statistical Analyses
Supplementary Materials
Author Contributions
Funding
Data Availability Statement
Acknowledgments
Conflicts of Interest
References
- Gechev, T.; Petrov, V. Reactive oxygen species and abiotic stress in plants. Int. J. Mol. Sci. 2020, 21, 7433. [Google Scholar] [CrossRef]
- Chen, Y.; Ebenstein, A.; Greenstone, M.; Li, H. Evidence on the impact of sustained exposure to air pollution on life expectancy from China’s Huai River policy. Proc. Natl. Acad. Sci. USA 2013, 110, 12936–12941. [Google Scholar] [CrossRef]
- Liu, W.; Liang, L.; Zhang, X.; Zhou, Q. Cultivar variations in cadmium and lead accumulation and distribution among 30 wheat (Triticum aestivum L.) cultivars. Environ. Sci. Pollut. Res. 2015, 22, 8432–8441. [Google Scholar] [CrossRef]
- Soodan, R.K.; Pakade, Y.B.; Nagpal, A.; Katnoria, J.K. Analytical techniques for estimation of heavy metals in soil ecosystem: A tabulated review. Talanta 2014, 125, 405–410. [Google Scholar] [CrossRef] [PubMed]
- Peralta-Videa, J.R.; Lopez, M.L.; Narayan, M.; Saupe, G.; Gardea-Torresdey, J. The biochemistry of environmental heavy metal uptake by plants: Implications for the food chain. Int. J. Biochem. Cell Biol. 2009, 41, 1665–1677. [Google Scholar] [CrossRef] [PubMed]
- El-Akhal, M.R.; Rincón, A.; Coba de la Peña, T.; Lucas, M.M.; El Mourabit, N.; Barrijal, S.; Pueyo, J.J. Effects of salt stress and rhizobial inoculation on growth and nitrogen fixation of three peanut cultivars. Plant Biol. 2013, 15, 415–421. [Google Scholar] [CrossRef] [PubMed]
- Guida-Johnson, B.; Zuleta, G.A. Land-use land-cover change and ecosystem loss in the Espinal Ecoregion, Argentina. Agric. Ecosyst. Environ. 2013, 181, 31–40. [Google Scholar] [CrossRef]
- Manousaki, E.; Kokkali, F.; Kalogerakis, N. Influence of salinity on lead and cadmium accumulation by the salt cedar (Tamarix smyrnensis Bunge): Phytoextraction by Tamarix smyrnensis Bunge. J. Chem. Technol. Biotechnol. 2009, 84, 877–883. [Google Scholar] [CrossRef]
- Mittler, R.; Blumwald, E. Genetic engineering for modern agriculture: Challenges and perspectives. Annu. Rev. Plant Biol. 2010, 61, 443–462. [Google Scholar] [CrossRef] [PubMed]
- Lefèvre, I.; Marchal, G.; Meerts, P.; Corréal, E.; Lutts, S. Chloride salinity reduces cadmium accumulation by the Mediterranean halophyte species Atriplex halimus L. Environ. Exp. Bot. 2009, 65, 142–152. [Google Scholar] [CrossRef]
- Zaier, H.; Ghnaya, T.; Lakhdar, A.; Baioui, R.; Ghabriche, R.; Mnasri, M.; Sghair, S.; Lutts, S.; Abdelly, C. Comparative study of Pb-phytoextraction potential in Sesuvium portulacastrum and Brassica juncea: Tolerance and accumulation. J. Hazard. Mater. 2010, 183, 609–615. [Google Scholar] [CrossRef] [PubMed]
- Amari, T.; Ghnaya, T.; Debez, A.; Taamali, M.; Ben Youssef, N.; Lucchini, G.; Sacchi, G.A.; Abdelly, C. Comparative Ni tolerance and accumulation potentials between Mesembryanthemum crystallinum (Halophyte) and Brassica juncea: Metal accumulation, nutrient status and photosynthetic activity. J. Plant Physiol. 2014, 171, 1634–1644. [Google Scholar] [CrossRef]
- Taamalli, M.; Ghabriche, R.; Amari, T.; Mnasri, M.; Zolla, L.; Lutts, S.; Abdely, C.; Ghnaya, T. Comparative study of Cd tolerance and accumulation potential between Cakile maritima L. (Halophyte) and Brassica juncea L. Ecol. Eng. 2014, 71, 623–627. [Google Scholar] [CrossRef]
- Jithesh, M.N.; Prashanth, S.R.; Sivaprakash, K.R.; Parida, A. Monitoring expression profiles of antioxidant genes to salinity, iron, oxidative, light and hyperosmotic stresses in the highly salt tolerant grey mangrove, Avicennia marina (Forsk.) Vierh. by mRNA analysis. Plant Cell Rep. 2006, 25, 865–876. [Google Scholar] [CrossRef] [PubMed]
- Manousaki, E.; Kalogerakis, N. Halophytes present new opportunities in phytoremediation of heavy metals and saline soils. Ind. Eng. Chem. Res. 2011, 50, 656–660. [Google Scholar] [CrossRef]
- Pérez-Chaca, M.V.; Rodríguez-Serrano, M.; Molina, A.S.; Pedranzani, H.E.; Zirulnik, F.; Sandalio, L.M.; Romero-Puertas, M.C. Cadmium induces two waves of reactive oxygen species in G Lycine max (L.) roots: Cadmium oxidative stress in Glycine max (L.). Plant Cell Environ. 2014, 37, 1672–1687. [Google Scholar] [CrossRef] [PubMed]
- Pérez Chaca, M.V.; Vigliocco, A.; Reinoso, H.; Molina, A.; Abdala, G.; Zirulnik, F.; Pedranzani, H. Effects of cadmium stress on growth, anatomy and hormone contents in Glycine max (L.) Merr. Acta Physiol. Plant. 2014, 36, 2815–2826. [Google Scholar] [CrossRef]
- Seneviratne, M.; Rajakaruna, N.; Rizwan, M.; Madawala, H.M.S.P.; Ok, Y.S.; Vithanage, M. Heavy metal-induced oxidative stress on seed germination and seedling development: A critical review. Environ. Geochem. Health 2019, 41, 1813–1831. [Google Scholar] [CrossRef]
- El Rasafi, T.; Oukarroum, A.; Haddioui, A.; Song, H.; Kwon, E.E.; Bolan, N.; Tack, F.M.G.; Sebastian, A.; Prasad, M.N.V.; Rinklebe, J. Cadmium stress in plants: A critical review of the effects, mechanisms, and tolerance strategies. Crit. Rev. Environ. Sci. Technol. 2022, 52, 675–726. [Google Scholar] [CrossRef]
- García de la Torre, V.S.; Coba de la Peña, T.; Pueyo, J.J.; Lucas, M.M. Cadmium-tolerant and -sensitive cultivars identified by screening of Medicago truncatula germplasm display contrasting responses to cadmium stress. Front. Plant Sci. 2021, 12, 595001. [Google Scholar] [CrossRef]
- Romero-Puertas, M.C.; Terrón-Camero, L.C.; Peláez-Vico, M.Á.; Olmedilla, A.; Sandalio, L.M. Reactive oxygen and nitrogen species as key indicators of plant responses to Cd stress. Environ. Exp. Bot. 2019, 161, 107–119. [Google Scholar] [CrossRef]
- Cuypers, A.; Plusquin, M.; Remans, T.; Jozefczak, M.; Keunen, E.; Gielen, H.; Opdenakker, K.; Nair, A.R.; Munters, E.; Artois, T.J.; et al. Cadmium stress: An oxidative challenge. Biometals 2010, 23, 927–940. [Google Scholar] [CrossRef]
- García de la Torre, V.S.; Coba de la Peña, T.; Lucas, M.M.; Pueyo, J.J. Transgenic Medicago truncatula plants that accumulate proline display enhanced tolerance to cadmium stress. Front. Plant Sci. 2022, 13, 829069. [Google Scholar] [CrossRef] [PubMed]
- Coba de la Peña, T.; Pueyo, J.J. Legumes in the reclamation of marginal soils, from cultivar and inoculant selection to transgenic approaches. Agron. Sustain. Dev. 2012, 32, 65–91. [Google Scholar] [CrossRef]
- Frérot, H.; Lefèbvre, C.; Gruber, W.; Collin, C.; Santos, A.D.; Escarré, J. Specific interactions between local metallicolous plants improve the phytostabilization of mine soils. Plant Soil 2006, 282, 53–65. [Google Scholar] [CrossRef]
- Udvardi, M.; Poole, P.S. Transport and metabolism in legume-rhizobia symbioses. Annu. Rev. Plant Biol. 2013, 64, 781–805. [Google Scholar] [CrossRef] [PubMed]
- Fernández-Pascual, M.; Pueyo, J.J.; Felipe, M.R.; Golvano, M.P.; Lucas, M.M. Singular features of the Bradyrhizobium-Lupinus symbiosis. Dyn. Soil Dyn. Plant 2007, 1, 1–16. [Google Scholar]
- Quiñones, M.A.; Ruiz-Díez, B.; Fajardo, S.; López-Berdonces, M.A.; Higueras, P.L.; Fernández-Pascual, M. Lupinus albus plants acquire mercury tolerance when inoculated with an Hg-resistant Bradyrhizobium strain. Plant Physiol. Biochem. 2013, 73, 168–175. [Google Scholar] [CrossRef] [PubMed]
- Dardanelli, M.S.; González, P.S.; Medeot, D.B.; Paulucci, N.S.; Bueno, M.Á.; Garcia, M.B. Effects of peanut rhizobia on the growth and symbiotic performance of Arachis hypogaea under abiotic stress. Symbiosis 2009, 47, 175–180. [Google Scholar] [CrossRef]
- Fabra, A.; Castro, S.; Taurian, T.; Angelini, J.; Ibañez, F.; Dardanelli, M.; Tonelli, M.; Bianucci, E.; Valetti, L. Interaction among Arachis hypogaea L. (peanut) and beneficial soil microorganisms: How much is it known? Crit. Rev. Microbiol. 2010, 36, 179–194. [Google Scholar] [CrossRef]
- Tesfaye, M.; Silverstein, K.A.T.; Bucciarelli, B.; Samac, D.A.; Vance, C.P. The Affymetrix Medicago GeneChip® array is applicable for transcript analysis of alfalfa (Medicago sativa). Funct. Plant Biol. 2006, 33, 783. [Google Scholar] [CrossRef] [PubMed]
- Pagliaricci, H.R.; Saroff, A.C.; Ohanian, A.E. Densidad de plantas y producción de forraje. Rev. Arg. Prod. Anim. 1991, 11, 285–293. [Google Scholar]
- Wang, D.; Khurshid, M.; Min Sun, Z.; Xiong Tang, Y.; Liang Zhou, M.; Min Wu, Y. Genetic engineering of alfalfa (Medicago sativa L.). Protein Pept. Lett. 2016, 23, 495–502. [Google Scholar] [CrossRef] [PubMed]
- Dincă, N.; Dunea, D.; Stanciu, A.-M.; Pătru, N. Testing a selection of alfalfa varieties for ecological plasticity, productivity and a number of qualitative parameters. Sci. Papers 2021, LXIV, 302–307. [Google Scholar]
- Kelner, D.J.; Vessey, J.K.; Entz, M.H. The nitrogen dynamics of 1-, 2- and 3-year stands of alfalfa in a cropping system. Agric. Ecosyst. Environ. 1997, 64, 1–10. [Google Scholar] [CrossRef]
- Townsend, M.S.; Henning, J.A.; Currier, C.G. The ALFALFA CATALOG software package. Agron. J. 1994, 86, 337–339. [Google Scholar] [CrossRef]
- Greenway, H.; Munns, R. Mechanisms of salt tolerance in nonhalophytes. Annu. Rev. Plant. Physiol. 1980, 31, 149–190. [Google Scholar] [CrossRef]
- Smolders, E.; Lambregts, R.M.; McLaughlin, M.J.; Tiller, K.G. Effect of soil solution chloride on cadmium availability to Swiss chard. J. Environ. Qual. 1998, 27, 426–431. [Google Scholar] [CrossRef]
- Weggler-Beaton, K.; McLaughlin, M.J.; Graham, R.D. Salinity increases cadmium uptake by wheat and Swiss chard from soil amended with biosolids. Soil Res. 2000, 38, 37–46. [Google Scholar] [CrossRef]
- Ghallab, A.; Usman, A.R.A. Effect of sodium chloride-induced salinity on phyto-availability and speciation of Cd in soil solution. Water Air Soil Pollut. 2007, 185, 43–51. [Google Scholar] [CrossRef]
- Ondrasek, G. Water scarcity and water stress in agriculture. In Physiological Mechanisms and Adaptation Strategies in Plants under Changing Environment; Ahmad, P., Wani, M.R., Eds.; Springer: New York, NY, USA, 2013; pp. 75–96. ISBN 978-1-4614-8590-2. [Google Scholar]
- Singh, B.R.; McLaughlin, M.J. Cadmium in soils and plants. A global perspective. In Cadmium in Soils and Plants; McLaughlin, M.J., Singh, B.R., Eds.; Springer Science + Bussiness Media: Berlin, Germany, 1999; pp. 1–9. [Google Scholar]
- Mühling, K.H.; Läuchli, A. Interaction of NaCl and Cd stress on compartmentation pattern of cations, antioxidant enzymes and proteins in leaves of two wheat genotypes differing in salt tolerance. Plant Soil 2003, 253, 219–231. [Google Scholar] [CrossRef]
- Ghnaya, T.; Slama, I.; Messedi, D.; Grignon, C.; Ghorbel, M.H.; Abdelly, C. Effects of Cd2+ on K+, Ca2+ and N uptake in two halophytes Sesuvium portulacastrum and Mesembryanthemum crystallinum: Consequences on growth. Chemosphere 2007, 67, 72–79. [Google Scholar] [CrossRef] [PubMed]
- Zhang, C.; Sale, P.W.G.; Tang, C. Cadmium uptake by Carpobrotus rossii (Haw.) Schwantes under different saline conditions. Environ. Sci. Pollut. Res. 2016, 23, 13480–13488. [Google Scholar] [CrossRef] [PubMed]
- Glaeser, S.P.; Imani, J.; Alabid, I.; Guo, H.; Kumar, N.; Kämpfer, P.; Hardt, M.; Blom, J.; Goesmann, A.; Rothballer, M.; et al. Non-pathogenic Rhizobium radiobacter F4 deploys plant beneficial activity independent of its host Piriformospora indica. ISME J. 2016, 10, 871–884. [Google Scholar] [CrossRef] [PubMed]
- Alabid, I.; Hardt, M.; Imani, J.; Hartmann, A.; Rothballer, M.; Li, D.; Uhl, J.; Schmitt-Kopplin, P.; Glaeser, S.; Kogel, K.-H. The N-acyl homoserine-lactone depleted Rhizobium radiobacter mutant RrF4NM13 shows reduced growth-promoting and resistance-inducing activities in mono- and dicotyledonous plants. J. Plant Dis. Prot. 2020, 127, 769–781. [Google Scholar] [CrossRef]
- Shvaleva, A.; de la Peña, T.C.; Rincón, A.; Morcillo, C.N.; de la Torre, V.S.G.; Lucas, M.M.; Pueyo, J.J. Flavodoxin overexpression reduces cadmium-induced damage in alfalfa root nodules. Plant Soil 2010, 326, 109–121. [Google Scholar] [CrossRef]
- Redondo, F.J.; de la Peña, T.C.; Lucas, M.M.; Pueyo, J.J. Alfalfa nodules elicited by a flavodoxin-overexpressing Ensifer meliloti strain display nitrogen-fixing activity with enhanced tolerance to salinity stress. Planta 2012, 236, 1687–1700. [Google Scholar] [CrossRef]
- Mushtaq, Z.; Faizan, S.; Gulzar, B.; Hakeem, K.R. Inoculation of Rhizobium alleviates salinity stress through modulation of growth characteristics, physiological and biochemical attributes, stomatal activities and antioxidant defence in Cicer arietinum L. J. Plant Growth Regul. 2021, 40, 2148–2163. [Google Scholar] [CrossRef]
- Quiñones, M.A.; Fajardo, S.; Fernández-Pascual, M.; Lucas, M.M.; Pueyo, J.J. Nodulated white lupin plants growing in contaminated soils accumulate unusually high mercury concentrations in their nodules, roots and especially cluster roots. Horticulturae 2021, 7, 302. [Google Scholar] [CrossRef]
- Jach, M.E.; Sajnaga, E.; Ziaja, M. Utilization of legume-nodule bacterial symbiosis in phytoremediation of heavy metal-contaminated soils. Biology 2022, 11, 676. [Google Scholar] [CrossRef]
- Sandalio, L.M.; Dalurzo, H.C.; Gómez, M.; Romero-Puertas, M.C.; Del Río, L.A. Cadmium-induced changes in the growth and oxidative metabolism of pea plants. J. Exp. Bot. 2001, 52, 2115–2126. [Google Scholar] [CrossRef] [PubMed]
- Ali, H.; Khan, E.; Ilahi, I. Environmental chemistry and ecotoxicology of hazardous heavy metals: Environmental persistence, toxicity, and bioaccumulation. J. Chem. 2019, 2019, 6730305. [Google Scholar] [CrossRef]
- Sies, H.; Berndt, C.; Jones, D.P. Oxidative stress. Annu. Rev. Biochem. 2017, 86, 715–748. [Google Scholar] [CrossRef] [PubMed]
- You, J.; Chan, Z. ROS Regulation during abiotic stress responses in crop plants. Front. Plant Sci. 2015, 6, 1092. [Google Scholar] [CrossRef] [PubMed]
- Wang, Y.; Zhang, Z.; Zhang, P.; Cao, Y.; Hu, T.; Yang, P. Rhizobium symbiosis contribution to short-term salt stress tolerance in alfalfa (Medicago sativa L.). Plant Soil 2016, 402, 247–261. [Google Scholar] [CrossRef]
- Grover, M.; Ali, S.Z.; Sandhya, V.; Rasul, A.; Venkateswarlu, B. Role of microorganisms in adaptation of agriculture crops to abiotic stresses. World J. Microbiol. Biotechnol. 2011, 27, 1231–1240. [Google Scholar] [CrossRef]
- Shrivastava, P.; Kumar, R. Soil salinity: A serious environmental issue and plant growth promoting bacteria as one of the tools for its alleviation. Saudi J. Biol. Sci. 2015, 22, 123–131. [Google Scholar] [CrossRef]
- Vogel-Mikuš, K.; Drobne, D.; Regvar, M. Zn, Cd and Pb accumulation and arbuscular mycorrhizal colonisation of Pennycress Thlaspi praecox Wulf. (Brassicaceae) from the vicinity of a lead mine and smelter in Slovenia. Environ. Pollut. 2005, 133, 233–242. [Google Scholar] [CrossRef]
- Baker, A.J.M. Accumulators and excluders—Strategies in the response of plants to heavy metals. J. Plant Nutr. 1981, 3, 643–654. [Google Scholar] [CrossRef]
- Chmielowska-Bak, J.; Gzyl, J.; Rucinska-Sobkowiak, R.; Arasimowick-Jelonek, M.; Deckert, J. The new insights into cadmium sensing. Front. Plant Sci. 2014, 5, 245. [Google Scholar] [CrossRef]
- Cobbett, C.S. Phytochelatin biosynthesis detoxification. Curr. Opin. Plant Biol. 2000, 3, 211–216. [Google Scholar] [CrossRef]
- Zitka, O.; Krystofova, O.; Sobrova, P.; Adam, V.; Zehnalek, J.; Beklova, M.; Kizek, R. Phytochelatin synthase activity as a marker of metal pollution. J. Hazard. Mat. 2011, 192, 794–800. [Google Scholar] [CrossRef] [PubMed]
- Pál, M.; Tajti, J.; Szalai, G.; Peeva, V.; Végh, B.; Janda, T. Interaction of polyamines, abscisic acid and proline under osmotic stress in the leaves of wheat plants. Sci. Rep. 2018, 8, 12839. [Google Scholar] [CrossRef] [PubMed]
- Ben Ammar, W.; Mediouni, C.; Tray, B.; Ghorbel, M.H.; Jemal, F. Glutathione and phytochelatin contents in tomato plants exposed to cadmium. Biol. Plant. 2008, 52, 314–320. [Google Scholar] [CrossRef]
- Kabir, A.H.; Hossain, M.M.; Khatun, M.A.; Mandal, A.; Haider, S.A. Role of silicon counteracting cadmium toxicity in alfalfa (Medicago sativa L.). Front. Plant Sci. 2016, 7, 1117. [Google Scholar] [CrossRef]
- Jozefczak, M.; Remans, T.; Vangronsveld, J.; Cuypers, A. Glutathione is a key player in metal-induced oxidative stress defenses. Int. J. Mol. Sci. 2012, 13, 3145–3175. [Google Scholar] [CrossRef]
- Loscos, J.; Naya, L.; Ramos, J.; Clemente, M.R.; Matamoros, M.A.; Becana, M. A reassessment of substrate specificity and activation of phytochelatin synthases from model plants by physiologically relevant metals. Plant Physiol. 2006, 140, 1213–1221. [Google Scholar] [CrossRef]
- Chen, J.; Liu, Y.-Q.; Yan, X.-W.; Wei, G.-H.; Zhang, J.-H.; Fang, L.-C. Rhizobium inoculation enhances copper tolerance by affecting copper uptake and regulating the ascorbate-glutathione cycle and phytochelatin biosynthesis-related gene expression in Medicago sativa seedlings. Ecotoxicol. Environ. Saf. 2018, 162, 312–323. [Google Scholar] [CrossRef]
- Majumdar, R.; Barchi, B.; Turlapati, S.A.; Gagne, M.; Minocha, R.; Long, S.; Minocha, S.C. Glutamate, ornithine, arginine, proline, and polyamine metabolic interactions: The pathway is regulated at the post-transcriptional level. Front. Plant Sci. 2016, 7, 78. [Google Scholar] [CrossRef]
- Hu, C.-A.A.; Delauney, A.J.; Verma, D.P.S. A bifunctional enzyme (Al-pyrroline-5-carboxylate synthetase) catalyzes the first two steps in proline biosynthesis in plants. Proc. Natl. Acad. Sci. USA 1992, 89, 9354–9358. [Google Scholar] [CrossRef]
- Maslennikova, D.; Nasyrova, K.; Chubukova, O.; Akimova, E.; Baymiev, A.; Blagova, D.; Ibragimov, A.; Lastochkina, O. Effects of Rhizobium leguminosarum Thy2 on the growth and tolerance to cadmium stress of wheat plants. Life 2022, 12, 1675. [Google Scholar] [CrossRef]
- Verdoy, D.; Coba De La Peña, T.; Redondo, F.J.; Lucas, M.M.; Pueyo, J.J. Transgenic Medicago truncatula plants that accumulate proline display nitrogen-fixing activity with enhanced tolerance to osmotic stress. Plant Cell Environ. 2006, 29, 1913–1923. [Google Scholar] [CrossRef]
- El Moukhtari, A.; Cabassa-Hourton, C.; Farissi, M.; Savouré, A. How does proline treatment promote salt stress tolerance during crop plant development? Front. Plant Sci. 2020, 11, 1127. [Google Scholar] [CrossRef] [PubMed]
- Sánchez, D.M.; Quejido, A.J.; Fernández, M.; Hernández, C.; Schmid, T.; Millán, R.; González, M.; Aldea, M.; Martín, R.; Morante, R. Mercury and trace element fractionation in Almadén soils by application of different sequential extraction procedures. Anal. Bioanal. Chem. 2005, 381, 1507–1513. [Google Scholar] [CrossRef] [PubMed]
- Hayat, S.; Hayat, Q.; Alyemeni, M.N.; Wani, A.S.; Pichtel, J.; Ahmad, A. Role of proline under changing environments: A review. Plant Signal. Behav. 2012, 7, 1456–1466. [Google Scholar] [CrossRef] [PubMed]
- Howieson, J.G.; Dilworth, M.J. Working with Rizobia; Australian Centre for International Agricultural Research: Canberra, Australia, 2016. [Google Scholar]
- Vincent, J.M. A Manual for Practical Study of Root Nodule Bacteria; International Biological Programme Handbook; Blackwell Scientific: Oxford, UK, 1970; ISBN 0-632-06410-2. [Google Scholar]
- Weisburg, W.G.; Barns, S.M.; Pelletier, D.A.; Lane, D.J. 16S Ribosomal DNA amplification for phylogenetic study. J. Bacteriol. 1991, 173, 697–703. [Google Scholar] [CrossRef] [PubMed]
- Jansen, E.; Michels, M.; van Til, M.; Doelman, P. Effects of heavy metals in soil on microbial diversity and activity as shown by the sensitivity-resistance index, an ecologically relevant parameter. Biol. Fertil. Soils 1994, 17, 177–184. [Google Scholar] [CrossRef]
- Singh, M.P.; Singh, D.K.; Rai, M. Assessment of growth, physiological and biochemical parameters and activities of antioxidative enzymes in salinity tolerant and sensitive basmati rice varieties. J. Agron. Crop Sci. 2007, 193, 398–412. [Google Scholar] [CrossRef]
- Beyer, W.F., Jr.; Fridovich, I. Assaying for superoxide dismutase activity: Some large consequences of minor changes in conditions. Anal. Biochem. 1987, 161, 559–566. [Google Scholar] [CrossRef]
- Redondo, F.J.; de la Peña, T.C.; Morcillo, C.N.; Lucas, M.M.; Pueyo, J.J. Overexpression of flavodoxin in bacteroids induces changes in antioxidant metabolism leading to delayed senescence and starch accumulation in alfalfa root nodules. Plant Physiol. 2009, 149, 1166–1178. [Google Scholar] [CrossRef]
- Zhang, X.-H.; Lin, A.-J.; Chen, B.-D.; Wang, Y.-S.; Smith, S.E.; Smith, F.A. Effects of Glomus mosseae on the toxicity of heavy metals to Vicia faba. J. Environ. Sci. 2006, 18, 721–726. [Google Scholar]
- Pfaffl, M.W. A new mathematical model for relative quantification in real-time RT-PCR. Nucleic Acids Res. 2001, 29, e45. [Google Scholar] [CrossRef] [PubMed]

| Isolate No. | MIC | |
|---|---|---|
| NaCl (mM) | CdCl2 (µM) | |
| 1 | >600 | <200 |
| 2 | >600 | <200 |
| 3 | >600 | <200 |
| 4 | >600 | >200 |
| 5 | >600 | >200 |
| 6 | >600 | >200 |
| 7 | >600 | <200 |
| 8 | >600 | <200 |
| 9 | >600 | <200 |
| 10 | >600 | <200 |
| Inoculation | Treatment | Inoculation × Treatment | |
|---|---|---|---|
| AFW | *** | *** | * |
| RFW | *** | *** | *** |
| Inoculation | Treatment | Inoculation × Treatment | |
|---|---|---|---|
| MDA | Ns | *** | Ns |
| SOD | Ns | * | Ns |
| CAT | * | *** | ** |
| Fertilization/Inoculation | Treatment | [Cd] (mg kg−1) | ||
|---|---|---|---|---|
| Leaves | Roots | TF | ||
| Fertilized | NaCl + CdCl2 | 11.81± 0.25 * | 901.71 ± 16.25 * | 1.31 |
| Inoculated | NaCl + CdCl2 | 9.52 ± 0.02 | 477.54 ± 3.58 | 1.99 |
| Inoculation | Treatment | Inoculation × Treatment | |
|---|---|---|---|
| MsCYS | Ns | * | *** |
| MsγECS | * | ** | * |
| MsGSHS | *** | *** | *** |
| MshGSHS | *** | Ns | Ns |
| MsPCS | Ns | * | Ns |
| MsP5CS1 | ** | Ns | Ns |
| MsP5CS2 | Ns | *** | *** |
| MsP5CR | Ns | Ns | *** |
| MsProDH | *** | * | Ns |
| MsOAT | Ns | Ns | *** |
Disclaimer/Publisher’s Note: The statements, opinions and data contained in all publications are solely those of the individual author(s) and contributor(s) and not of MDPI and/or the editor(s). MDPI and/or the editor(s) disclaim responsibility for any injury to people or property resulting from any ideas, methods, instructions or products referred to in the content. |
© 2023 by the authors. Licensee MDPI, Basel, Switzerland. This article is an open access article distributed under the terms and conditions of the Creative Commons Attribution (CC BY) license (https://creativecommons.org/licenses/by/4.0/).
Share and Cite
Pacheco-Insausti, M.C.; Ponce, I.T.; Quiñones, M.A.; Pedranzani, H.E.; Pueyo, J.J. Effects of Inoculation with Stress-Tolerant Rhizobia on the Response of Alfalfa (Medicago sativa L.) to Combined Salinity and Cadmium Stress. Plants 2023, 12, 3972. https://doi.org/10.3390/plants12233972
Pacheco-Insausti MC, Ponce IT, Quiñones MA, Pedranzani HE, Pueyo JJ. Effects of Inoculation with Stress-Tolerant Rhizobia on the Response of Alfalfa (Medicago sativa L.) to Combined Salinity and Cadmium Stress. Plants. 2023; 12(23):3972. https://doi.org/10.3390/plants12233972
Chicago/Turabian StylePacheco-Insausti, M. Cecilia, Ivana Tamara Ponce, Miguel A. Quiñones, Hilda E. Pedranzani, and José J. Pueyo. 2023. "Effects of Inoculation with Stress-Tolerant Rhizobia on the Response of Alfalfa (Medicago sativa L.) to Combined Salinity and Cadmium Stress" Plants 12, no. 23: 3972. https://doi.org/10.3390/plants12233972
APA StylePacheco-Insausti, M. C., Ponce, I. T., Quiñones, M. A., Pedranzani, H. E., & Pueyo, J. J. (2023). Effects of Inoculation with Stress-Tolerant Rhizobia on the Response of Alfalfa (Medicago sativa L.) to Combined Salinity and Cadmium Stress. Plants, 12(23), 3972. https://doi.org/10.3390/plants12233972

